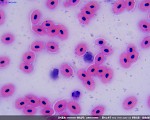
蛙血液

- 欢迎索取产品册
- 微视界品牌直供
- 4000-135-686


景通仪器的LCMOS相机系我们设计的一种豪华式采用超高性能的CMOS图像传感器作为图像采集设备的USB2.0 CMOS相机(luxurious USB2.0 CMOS),相机电路板上带有缓冲存贮器,稳定性好。LCMOS相机分辨率跨度大,自120万像到1400万像,C接口采用高等级不锈钢材质,确保经久耐用。
产品信息
- 采用Aptina CMOS传感器的C接口CMOS相机;
- 分辨率横跨1.2M~14M等多种;
- 板上集成有大容量存贮芯片,确保数据同步传输、高帧率以及稳定性;
- 高效散热结构,确保低噪声图像;
- USB2.0接口确保高传输速率;
- Ultra-Fine颜色引擎确保颜色精准再现;
- 随相机提供高级视频与图像处理应用软件ToupView;
- 提供Windows/Linux/OSX多平台SDK;
- 支持原生C/C++, C#, Directshow, Twain API;
LCMOS:景通仪器的LCMOS相机系我们设计的一种豪华式采用超高性能的CMOS图像传感器作为图像采集设备的USB2.0 CMOS相机(luxurious USB2.0 CMOS),相机电路板上带有缓冲存贮器,稳定性好。
LCMOS相机分辨率跨度大,自120万像到1400万像,C接口采用高等级不锈钢材质,确保经久耐用。
另外LCMOS采用USB2.0作为数据传输接口,传输速度中等,可用于显微数码照相等。
| 订购代码 | 传感器型号/尺寸 | 像素(μm) | G光灵敏度 动态范围 信噪比 |
FPS/分辨率 | 合并模式 | 曝光时间 |
|---|---|---|---|---|---|---|
| LCMOS14000KPA LP614000A |
MT9F002(C) 1/2.3"(6.451x4.603) | 1.4x1.4 | 0.724v/lux-sec 65.3dB 35.5dB |
2.7@4096x3288 10@2048x1644 35@1024x822 |
1x1,2x2,4x4 | 0.4ms~2000ms |
| LCMOS10000KPA LP610000A |
MT9J003(C) 1/2.3"(6.44x4.616) | 1.67x1.67 | 0.31v/lux-sec 65.2dB 34dB |
3.7@3584x2748 13@1792x1374 35@896x684 |
1x1,2x2,4x4 | 0.4ms~2000ms |
| LCMOS09000KPB LP609000B |
Special(C) 1/2.4"(5.825x4.369) | 1.67x1.67 | 0.31v/lux-sec 65.2dB 34dB |
3.9@3488x2616 15@1744x1308 47@872x654 |
1x1,2x2,4x4 | 0.4ms~2000ms |
| LCMOS08000KPB LP608000B |
Special(C) 1/2.5"(5.451x4.088) | 1.67x1.67 | 0.31v/lux-sec 65.2dB 34dB |
4.4@3264x2448 17@1600x1200 55@800x600 |
1x1,2x2,4x4 | 0.4ms~2000ms |
| LCMOS05100KPA LP605100A |
MT9P001(C) 1/2.5"(5.7x4.28) | 2.2x2.2 | 0.53 V/lux-sec 66.5dB 40.5dB |
6.8@2592x1944 18@1280x960 60@640x480 |
1x1,2x2,4x4 | 0.294ms~2000ms |
| LCMOS03100KPA LP603100A |
MT9T001(C) 1/2"(6.55x4.92) | 3.2x3.2 | 1.0 V/lux-sec 61dB 43dB |
11.5@2048x1536 32@1024x768 45@680x510 |
1x1,2x2,3x3 | 0.244ms~2000ms |
| LCMOS03100KPB LP603100B |
IMX036(C) 1/2.8"(5.36x3.97) | 2.5x2.5 | 200mv with 1/30s 0.5mv with 1/30s |
12@2048x1536 48@1024x768 48@680x5104 |
1x1,2x2,3x3 | 0.244ms~2000ms |
| LCMOS01300KPA LP601300A |
MT9M111(C) 1/3"(4.60x3.7) | 3.6x3.6 | 1.0 V/lux-sec 61dB 43dB |
15@1280x1024 26@640x512 48@320x256 |
1x1,2x2,4x4 | 0.14ms~2000ms |
| LCMOS01200KPB LP601200B |
AR0130(C) 1/3" (4.60x3.70) | 3.6x3.6 | 5.5v/lux-sec 85.3dB 44dB |
28@1280x960 30@640x480 |
1x1,2x2 | 0.14ms~2000ms |
| 硬件其他配置信息 | |
|---|---|
| 光谱响应范围 | 380-650nm (有红外截止滤光片情况下) |
| 白平衡 | ROI 白平衡/手动Temp-Tint调整 |
| 色彩还原技术 | Ultra-Fine颜色处理引擎 |
| 捕获/控制API | 原生 C/C++, C#, Directshow, Twain, Labview |
| 记录方式 | 图像和视频 |
| 制冷方式* | 自然冷却 |
| 相机工作环境 | |
| 工作温度(摄氏度) | -10℃~ 50℃ |
| 贮存温度(摄氏度) | -20℃~ 60℃ |
| 工作湿度 | 30~80%RH |
| 贮存湿度 | 10~60%RH |
| 供电电源 | 相机通过USB接口供电 |
| 软件运行环境 | |
| 操作系统 | Microsoft Windows XP / Vista / 7 /8 /10(32 & 64 bit) OS X (Mac OS X), Linux |
| 计算机配置 | CPU: Intel Core 2 2.8GHz 或更高 |
| 内存:2GB或更大 | |
| USB接口:USB2.0高速接口 | |
| 显示器:17”或以上 | |
| CD-ROM | |
LCMOS系列C接口USB2.0 CMOS相机外形尺寸示意图

LCMOS系列C接口USB2.0 CMOS相机外形尺寸示意图(点击放大)。相机壳体由坚硬铝合金机械加工而成,确保重负荷情况冲击。相机传感器的前端安装有高品质的IR-CUT,主要起到滤除成像中的红外光波,同时保护相机传感器作用。相比其他工业相机,景通仪器的相机无运动部件以确保相机坚固可靠、经久耐用,同时不存在由于运动部件抖动而引发的成像模糊。
包装清单

LCMOS 系列C接口USB2.0 CMOS相机包装清单
| 标准包装清单 | ||||
|---|---|---|---|---|
| A | 包装箱规格:L:50cm W:30cm H:30cm(20pcs, 12~17Kg/纸箱, 0.045m3),上图中未给出 | |||
| B | 包装盒规格:L:16.4cm W:16.4cm H:7.5cm (0.8~1.0Kg/ box) | |||
| C | LCMOS系列C接口USB2.0 CMOS相机 | |||
| D | 高速USB2.0 A公到B公镀金头数据线/2.0m | |||
| E | CD (Driver & utilities software, Ø12cm) | |||
| 可选附件 | ||||
| F | 可调焦式目镜筒适配器 | C接口转 Dia.23.2mm目镜筒 (请根据你的相机与显微镜选择其中之一) |
108001/AMA037 108002/AMA050 108003/AMA075 |
|
| C接口转 Dia.31.75mm目镜筒 (请根据你的相机与望远镜选择其中之一) |
108008/ATA037 108009/ATA050 108010/ATA075 |
|||
| G | 固定式目镜筒适配器 | C接口转 Dia.23.2mm目镜筒 (请根据你的相机与显微镜选择其中之一) |
108005/FMA037 108006/FMA050 108007/FMA075 |
|
| C接口转 Dia.31.75mm目镜筒 (请根据你的相机与望远镜选择其中之一) |
108011/FTA037 108012/FTA050 108013/FTA075 |
|||
| 注意: 对F和G选项, 请先确定你的相机型号(C接口,显微镜相机或望远镜相机), 景通仪器的工程师会根据你的应用帮助你选定合适的显微镜或望远镜适配器; | ||||
| H | 108015(Dia.23.2mm to 30.0mm环)/用于直径30mm目镜筒转接环 | |||
| I | 108016(Dia.23.2mm to 30.5mm环)/ 用于直径30.5mm目镜筒转接环 | |||
|
J
|
108017(Dia.23.2mm to 31.75mm环)/ 用于直径31.75目镜筒转接环 | |||
| K | 测微尺 | 106011/TS-M1(X=0.01mm/100Div.); 106012/TS-M2(X,Y=0.01mm/100Div.); 106013/TS-M7(X=0.01mm/100Div., 0.10mm/100Div.) |
||
LCMOS系列C接口USB2.0 CMOS相机转成显微镜或望远镜用电子目镜
| 扩展 | 图例 | |
|---|---|---|
| C接口相机 |  |
机器视觉; 医学成像; 半导体设备; 测试仪器; 文件扫描仪; 2D码扫描仪; Web相机或视频监控; 显微成像; |
| 显微镜电子目镜 |  |
|